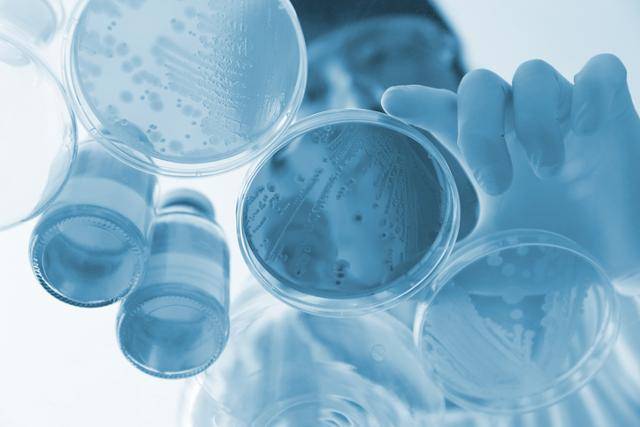
게티이미지뱅크

하천 범람·하수관 역류로 채소·지하수 오염 '식중독 주의보'
전체 맥락을 이해하기 위해서는 본문 보기를 권장합니다.
기록적인 폭우가 한반도를 할퀴면서 식중독 발생 위험도 덩달아 높아졌다.
식약처는 "특히 집단급식소와 음식점 조리사는 조리복을 입은 채 화장실을 이용하지 말고 가열조리‧교차오염 방지 등 식중독 예방수칙을 철저히 지켜야 한다"며 "집단급식소에서는 식중독 조기 경보시스템을 통해 '식중독 발생 시설에서 사용한 식재료와 동일하다'고 통보받으면 익힌 음식으로 변경해 제공하는 게 좋다"고 강조했다.
이 글자크기로 변경됩니다.
(예시) 가장 빠른 뉴스가 있고 다양한 정보, 쌍방향 소통이 숨쉬는 다음뉴스를 만나보세요. 다음뉴스는 국내외 주요이슈와 실시간 속보, 문화생활 및 다양한 분야의 뉴스를 입체적으로 전달하고 있습니다.
특히 병원성대장균 식중독 위험↑
개인위생 철저, 식품별 보관 방법 유념
기록적인 폭우가 한반도를 할퀴면서 식중독 발생 위험도 덩달아 높아졌다. 식재료 오염 때문이다. 집중호우로 하천이 범람하거나 하수관이 역류하면 유출된 분뇨나 퇴비 등이 채소와 지하수를 오염시켜 식중독을 일으킨다. 원래 식중독은 기온과 습도가 높은 여름철에 집중적으로 발생하는데, 올해는 115년 만에 폭우가 쏟아진 수도권 등 중부지방에서 이 같은 위험이 더욱 커졌다.
13일 식품의약품안전처에 따르면 최근 5년간 여름철(6~8월)에 발생한 식중독은 493건이다. 확인된 발병 원인으로는 병원성대장균이 109건(22%)으로 가장 많았다. 살모넬라로 인한 식중독은 52건(11%), 캠필로박터는 49건(10%), 노로바이러스는 36건(7%)이다.
동물의 대장에 흔하게 존재하는 병원성대장균은 고기를 충분히 가열하지 않고 섭취하거나 가축의 분뇨, 퇴비 등이 호우 등으로 유출될 때 사람에게 악영향을 끼친다. 최근 5년을 돌아보면 병원성대장균 식중독 109건으로 인한 환자는 4,695명이나 된다. 특히 8월에 54건이 발생해 2,745명의 환자가 발생했다. 발생 건수 대비 환자가 많은 이유는 학교 등 집단급식소를 중심으로 식중독이 퍼졌기 때문이다.

같은 기간 병원성대장균 식중독 가운데 원인식품이 확인된 사례는 48건(3,384명)인데, 의외로 고기보다 채소로 인한 식중독이 더 많았다. 김치, 생채류, 겉절이 등 익히지 않은 채소류 음식이 발병 원인인 식중독이 19건(2,118명)이다. 10건 중 4건이 채소로 인한 식중독이었다는 얘기다. 이어 김밥, 백반 등 다양한 원료가 포함된 복합조리식품이 10건(555명), 육류가 7건(138명)이다.
따라서 물에 잠겼거나 침수가 의심되는 식품, 특히 채소류는 절대로 먹지 말고 폐기해야 한다. 침수 피해지역이 아니더라도 고온다습한 여름철에는 채소를 세척한 뒤 실온에 두면 세척 전보다 세균이 더욱 증가한다는 점을 유의해야 한다. 조리한 음식이라도 2시간 이내에 먹는 게 좋고, 남은 음식은 냉장‧냉동실에 보관하고 다시 먹을 때는 충분한 온도로 재가열해야 한다.

식약처가 당부하는 식재료별 취급 방법
-채소: 샐러드나 생채 무침처럼 가열 조리하지 않고 섭취할 경우 염소 소독액(100ppm)에 5분 이상 담근 후 수돗물로 3회 이상 세척(100ppm은 유효염소 4% 염소소독제를 약 400배 희석한 농도)
-과일: 수박, 참외, 복숭아 등은 과일·채소용 세척제로 표면을 닦고 수돗물로 헹궈서 섭취
-고기: 핏물이 흘러나오지 않도록 밀폐용기에 넣어 냉장고 가장 아래 칸에 보관하고 다짐육은 75도에서 1분 이상 가열해 속까지 완전히 익도록 조리
-견과: 곰팡이가 발생하기 쉬워 밀봉 뒤 냉장 또는 냉동 보관
식약처는 "특히 집단급식소와 음식점 조리사는 조리복을 입은 채 화장실을 이용하지 말고 가열조리‧교차오염 방지 등 식중독 예방수칙을 철저히 지켜야 한다"며 "집단급식소에서는 식중독 조기 경보시스템을 통해 '식중독 발생 시설에서 사용한 식재료와 동일하다'고 통보받으면 익힌 음식으로 변경해 제공하는 게 좋다"고 강조했다.

김창훈 기자 chkim@hankookilbo.com
Copyright © 한국일보. 무단전재 및 재배포 금지.
- 민주당 전대 흔드는 '개딸'들... '팬덤 정치'의 빛과 그림자
- 폭우도 그녀들을 막지 못했다…우리 회사엔 '골때녀'가 있다!
- 尹, 지지율 하락 멈췄지만... '재난 대응' 논란에 대통령실 개편론
- 원희룡 "반지하도 사람 사는 곳 없애면 어디로 가나"
- 매일 새벽 네시에 깨는 당신, 단순 불면증이 아닙니다
- 태풍'메아리' 나비효과…주말 또 120㎜ 물폭탄 쏟아진다
- 윤 대통령 아파트가 침수 피해?... '허위 영상'에 뿔난 입주민들
- "폭우가 남긴 건 쓰레기뿐"... 팍팍한 세상, 이웃 손길에 다시 힘낸다
- 폭우 때 급류 휩쓸려 사망했는데 ‘수해 피해자’ 아니다?
- '1200원대 휘발유' 출혈 경쟁…주유소 사장님들 왜 그랬을까